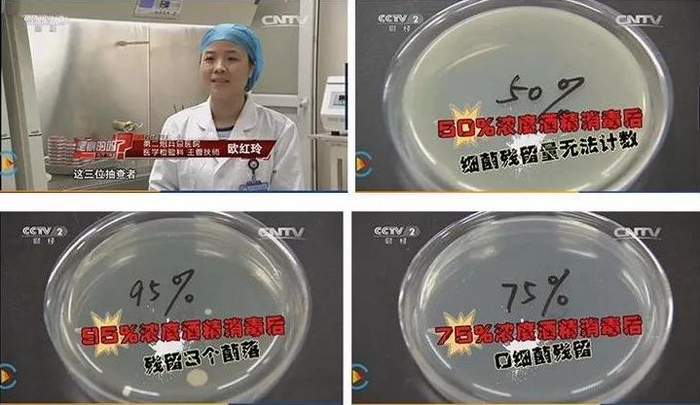

这段时间最紧缺的除了口罩,就是日常消毒用品了。
今天我们好不容易找到了一款消毒神器—— 国光75%酒精消毒湿巾 ,它由国内知名企业生产制作,是国家认可的良心产品,很多家疫区医院都指定采购。
它不仅含有可以杀死绝大部分细菌病毒的75%浓度酒精,还含有RO纯化水,双重杀毒,给你双重保护。
作为一款消毒湿巾,它的使用范围非常的广,而且方便携带,不管是居家还是外出,都能给你一份安心。需要的朋友可得赶紧下手~
这些天,确诊的病例数字还在上升,看的令人有些揪心。

目前已知的细菌传染途径有3种:分别是口液、飞沫和接触传播。
我们每天触摸佩戴口罩,可以有效阻挡口液和飞沫的传播,而目前最容易让人忽视的,就是接触传播!
2月3日上午,广州疾控中心,竟然在一名患者家中的门把手上,发现了新冠病毒的踪迹。

还有杭州的新闻,一男子在短短50秒的时间里,取药过程中感染病毒!

而能有效预防接触传播的办法就是:
洗手,消毒,对有你需要接触的东西进行消毒!
据李兰娟院士解答:这次的新冠病毒,病毒本身对外界的抵抗力不强,75%的酒精是能够消灭这个病毒的。

人民日报,央视新闻等媒体也经过大量的报道,把这一消息普及给人民大众。

所以日常需要接触的地方,是非常有必要用75%酒精去进行消毒的。
为什么一定要75%浓度呢?小小科普一下:
这是因为,过高浓度酒精会在细菌表面形成一层保护膜,阻止其进入细菌体内,难以将细菌彻底杀死。
若酒精浓度过低,虽可进入细菌,但不能将其体内的蛋白质凝固,同样也不能将细菌彻底杀死。
经实验证明,75%浓度的酒精效果最好,不要多,也不能少。
因为现在消毒产品需求特别大,很多消毒产品都断货了,后台也一直有粉丝询问。
这几天我也没闲着,积极给大家争取日用消毒用品,现在终于争取到了一款消毒神物——国光75%酒精消毒湿巾 。

它由国内知名企业杭州国光药业生产制作,是国光集团旗下子公司,成立于2000年,一直以来口碑都非常的好。
在GMP10万级洁净生产车间生产,是国家认可的良心产品,很多家疫区医院都指定采购。


除了75%浓度酒精之外,它还搭配采用了RO纯水,经过SGS检测,这款湿巾的抑菌率达到99%。
不管是日常使用还是办公使用或者出行,都是非常方便可靠的。


【国光75%酒精消毒湿巾】
75%医用酒精含量
RO纯水物理灭菌
0添加荧光增白剂
全场景使用,亲肤温和无刺激
原价129元/3包
老牛特惠价:
89元/3包(每包50片)
立即购买
▼
相较于消毒液,消毒湿巾的优点!
日常消毒品大家更常见的可能是消毒液,但消毒液使用起来比较麻烦,需要配置溶液,需要用抹布来蘸取擦物品。
它不仅可以方便日常携带,平常外出就可以放在包里,还可以直接拿出来使用,擦起来也更全面无死角。
还能当平时的湿巾使用,一举多得。

而且使用一次一张的消毒湿巾,根本不需要像消毒液那样担心误配的发生,也不会因为抹布反复使用而造成的交叉感染。

许多人平常就有携带湿巾的习惯,但普通的湿巾,没有杀菌效果。
就算有些卫生湿巾,杀菌率也只有70%左右,这款国光消毒湿巾,杀菌率高达99%,绝对是居家和外出的必备。
双重消毒,还对人体非常安全!
孕妇、小孩都可直接使用
这款国光酒精湿巾的成分中,还含有RO纯化水。
这种水经过6次的循环处理,可做到物理灭杀细菌的效果。
75%酒精+RO纯化水,双重杀毒,给你双重保护。

既然是可以对皮肤直接使用的产品,就要让人感觉舒适自然,没有伤害。
所以这款湿巾的布料采用的是水刺无纺布,具有柔软舒适,高吸湿性,强透气性,低起毛性等特点。
使用起来异常柔和,不伤及皮肤。

当然也不掉絮,用力依然扯不破,比毛巾更卫生,比纸巾更柔韧!

还有一点非常重要,就是这款湿巾的液体里一点有害的材料都没加,就连对皮肤没有刺激性的荧光增白剂这种东西也没有。
要知道,一般的湿巾里都会添加荧光增白剂的,可是,国光酒精湿巾一点点都没添加,就是为了更加安全。

材质不但要手感舒适,更重要的是在释放消毒因子的时候没有任何的阻碍。
这样的酒精湿巾,即便是孕妇,小孩,也照样可以直接使用,完全不用担心。

【国光75%酒精消毒湿巾】
75%医用酒精含量
RO纯水物理灭菌
0添加荧光增白剂
全场景使用,亲肤温和无刺激
原价129元/3包
老牛特惠价:
89元/3包(每包50片)
立即购买
▼
能多场景使用,给你多份安心!
肺炎疫情疯狂当前,我们接触公共物品、一定要先擦拭、消毒,防患于未然!
而在方便这一块,国光消毒湿巾,随时随地能提供随时随地的个人防护。它的使用范围真的非常的广,下面这些地方它都可以用!

去超市、去菜场,口罩挡住了空气唾沫传播,但双手难免接触了很多细菌,酒精消毒湿巾,随手一擦,擦出安心感。

消毒用具也很重要,隔离在家,门把手、桌子、便盆、马桶……随手一擦,让病菌远离。

要是开工了去公司办公,电脑、鼠标、办公桌擦一擦,安全更放心。

在返程的火车或者飞机上,孩子要吃东西,最好用它擦一擦。

因为很多消毒产品都断货了,还是希望这款产品能带给大家多一份守护。
而且厂家也没有提价,3包只要89元,每包有50片,相比较自己的健康还是很划算的。
抗击病毒,是一场没有硝烟的战争。在这个很多物资紧缺的特殊时候,能买到就是赚到。
只要我们勤洗手,多消毒,做好自己的个人卫生,小小的病毒必将倒在我们的脚下!
【国光75%酒精消毒湿巾】
75%医用酒精含量
RO纯水物理灭菌
0添加荧光增白剂
全场景使用,亲肤温和无刺激
原价129元/3包
老牛特惠价:
89元/3包(每包50片)


